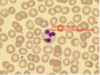
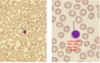
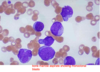
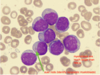
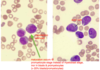
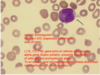
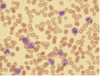
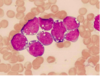
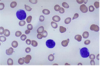
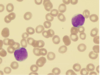
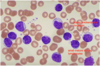
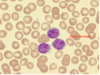
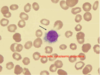
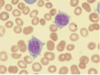
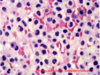
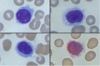
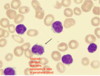
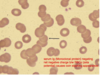

Heme 3 Flashcards
(39 cards)
1
Q

A
Myeloblast
2
Q

A
Promyelocyte
3
Q

A
Neutrophilic Myelocyte
4
Q

A
Neutrophilic Metamyelocyte
5
Q

A
Neutrophilic Band
6
Q
A
Mature Neutrophil
7
Q
A
Lymphocyte
8
Q

A
Acute Myeloid Leukemia

9
Q
A
Acute Myeloid Leukemia
10
Q
A
Acute Myeloid Leukemia

11
Q
A
Acute Promyelocytic Leukemia (M3 AML)
12
Q

A
M4/5 AML
13
Q

A
Chronic Myelogenous Leukemia
-Philadelphia chromosome (9, 22)

14
Q

A
Chronic Myelogenous Leukemia

15
Q

A
Chronic Myelogenous Leukemia

16
Q
A
Chronic Myelogenous Leukemia
17
Q

A
Acute Lymphoblastic Leukemia (ALL)
18
Q

A
Acute Lymphoblastic Leukemia (ALL)
19
Q
A
Acute Lymphoblastic Leukemia (ALL)
20
Q

A
Chronic Lymphocytic Leukemia (CLL)

21
Q
A
Chronic Lymphocytic Leukemia (CLL)
22
Q
A
Hairy Cell Leukemia
23
Q
A
Hairy Cell Leukemia

24
Q
A
Hairy Cell Leukemia
25

Hodgkin's Lymphoma

26

Hodgkin's Lymphoma

27

Hodgkin's Lymphoma
-Nodular Sclerosis

28

Hodgkin's Lymphoma
-Nodular Sclerosis
29

Normal LN

30

NHL- Follicular Lymphoma

31

NHL- Follicular Lymphoma
32

Diffuse Large B Cell Lymphoma (NHL)
33

Burkitt Lymphoma (NHL)
34

Burkitt Lymphoma (NHL)

35

Multiple Myeloma

36

Multiple Myeloma

37

Multiple Myeloma
-bone lesions

38

Multiple Myeloma
-bone lesions, Rouleaux formation
39

Multiple Myeloma
-M spike